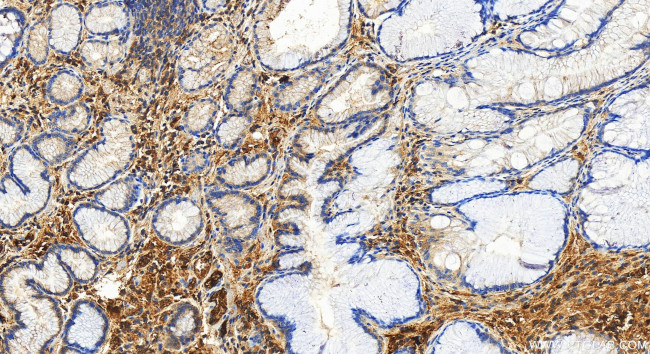
Serum amyloid P component Antibody in Immunohistochemistry (Paraffin) (IHC (P))

Search
Proteintech
Serum amyloid P component Polyclonal Antibody
{{$productOrderCtrl.translations['antibody.pdp.commerceCard.promotion.promotions']}}
{{$productOrderCtrl.translations['antibody.pdp.commerceCard.promotion.viewpromo']}}
{{$productOrderCtrl.translations['antibody.pdp.commerceCard.promotion.promocode']}}: {{promo.promoCode}} {{promo.promoTitle}} {{promo.promoDescription}}. {{$productOrderCtrl.translations['antibody.pdp.commerceCard.promotion.learnmore']}}
图: 1 / 4
Serum amyloid P component Antibody (31813-1-AP) in IHC (P)




产品信息
31813-1-AP
种属反应
宿主/亚型
分类
类型
抗原
偶联物
形式
浓度
规格
纯化类型
保存液
内含物
保存条件
运输条件
靶标信息
The protein encoded by this gene is a glycoprotein, belonging to the pentraxin family of proteins, which has a characteristic pentameric organization. These family members have considerable sequence homology which is thought to be the result of gene duplication. The binding of the encoded protein to proteins in the pathological amyloid cross-beta fold suggests its possible role as a chaperone. This protein is also thought to control the degradation of chromatin. It has been demonstrated that this protein binds to apoptotic cells at an early stage, which raises the possibility that it is involved in dealing with apoptotic cells in vivo.
仅用于科研。不用于诊断过程。未经明确授权不得转售。
篇参考文献 (0)
生物信息学
蛋白别名: 9.5S alpha-1-glycoprotein; APCS; epididymis secretory sperm binding protein Li 92n; MGC88159; Pentaxin related; pentaxin-related; Pentraxin 2; pentraxin-2; pentraxin-related; pre-serum amyloid P component; PTX 2; SAMP; SAP; Serum amyloid P-component; unnamed protein product
基因别名: APCS; HEL-S-92n; PTX2; SAP
UniProt ID: (Human) P02743
Entrez Gene ID: (Human) 325